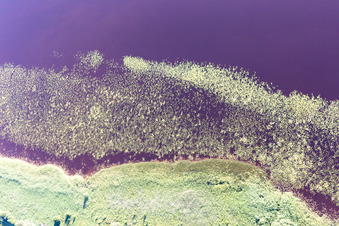
Torne in the state Kronoberg, Sweden viewn from the air

Markers and pins are where there are aerial photos:
 zoomes there,
zoomes there,  to the aerial there,
to the aerial there,  to the album of the neighboring town.
to the album of the neighboring town.
Please order your aerial photographs of Germany here.
(If you have aerial photos from other countries in the online shop's shopping cart, please pay in the Online shop checkout .)
(If you have aerial photos from other countries in the online shop's shopping cart, please pay in the Online shop checkout .)